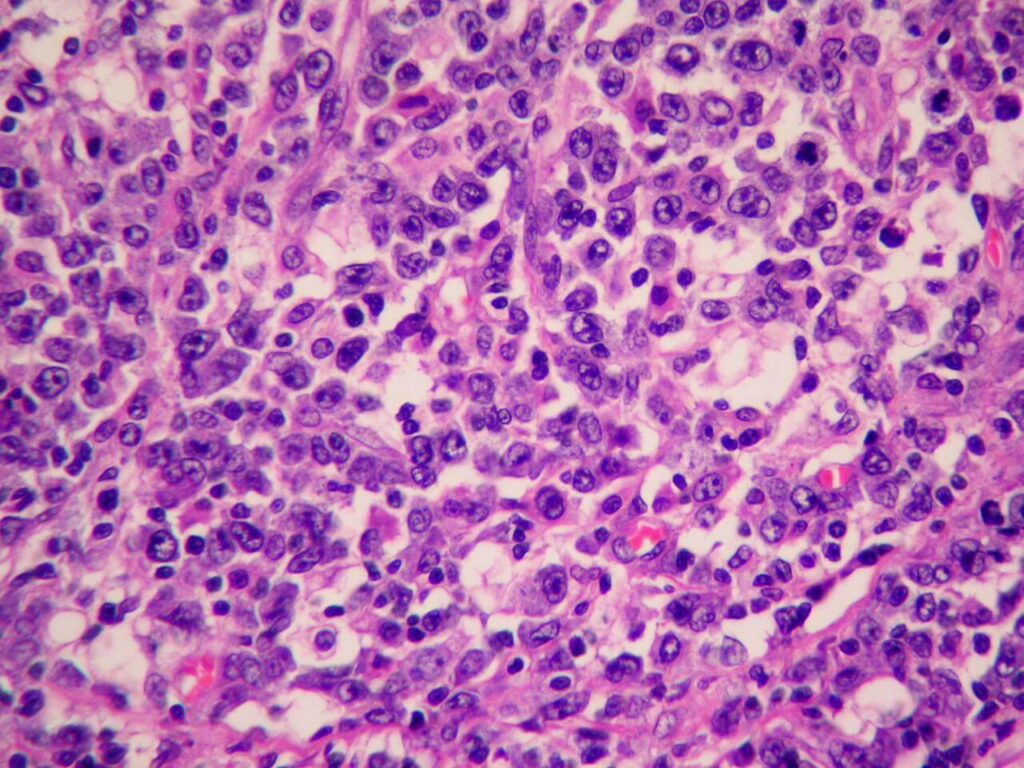

Рецензент
Анапластична лімфома – це онкозахворювання, при якому злоякісними стають Т-лімфоцити. Ця онкопатологія не є видом раку молочних залоз, але злоякісний процес може розвиватися в області грудей – у пацієнтів з імплантами. За медичною класифікацією, це один з типів неходжкінської лімфоми.
Як проявляється крупноклітинна лімфома
Великоклітинна анапластична лімфома – рідкісне захворювання. Зокрема, згідно зі статистикою, в Італії частота BIA – ALCL (анапластичної великоклітинної лімфоми, пов’язаної з грудним імплантом) складає приблизно 3,5 випадків на 100 000 пацієнтів з імплантами. А у всьому світі на 2022 рік було зареєстровано більше 1216 випадків. Крім BIA – ALCL, існують інші підтипи периферичної Т-клітинної лімфоми – типу неходжкінської лімфоми. Це первинна шкірна анапластична лімфома, системна ALK-позитивна (ALK +ve) та негативна (ALK -ve) анапластичні лімфоми.
Причини, особливості перебігу хвороби, її лікування вимагає подальших численних досліджень. Але наразі відомо, що при анапластичній великоклітинній лімфомі можливі такі симптоми:
- Розвиток пізньої сероми, що супроводжується збільшенням розміру аугментованої молочної залози, набряком молочної залози, почервонінням, болем;
- Поява пальпованого новоутворення у молочній залозі, у товщі сполучнотканинної капсули навколо імпланта;
- Збільшення лімфатичних вузлів;
- Підвищена схильність до кровотеч та утворення синців;
- Шкірний свербіж;
- Загальна слабкість.
При інших формах крупноклітинної лімфоми злоякісний процес локалізується в інших ділянках тіла.
Діагностика крупноклітинної лімфоми
Якщо є підозра на лімфому після мамопластики, пацієнту необхідна консультація мамолога – з оглядом і пальпацією молочних залоз, лімфовузлів, ретельним збором анамнезу, а також інструментальна та лабораторна діагностика:
- УЗД молочної залози;
- Мамографія;
- МРТ молочних залоз;
- КТ – для виявлення інших можливих осередків розвитку злоякісного процесу в організмі;
- Біопсія виявленого новоутворення для проведення гістологічного, імуногістохімічного аналізу;
- Біопсія лімфовузлів;
- Загальний аналіз крові та інші лабораторні дослідження;
- Консультація гематолога і деяких інших спеціалістів вузького профілю.
Лікування анапластичної крупноклітинної лімфоми
Агресивна великоклітинна лімфома вимагає швидкого початку лікування та комплексного підходу у боротьбі з нею.
- На ранніх стадіях розвитку проводиться операція, під час якої видаляється імплант разом з утвореною навколо нього сполучнотканинною капсулою (після вилучення вона відправляється до лабораторії для проведення аналізів). Також проводиться лімфодисекція – видалення уражених лімфовузлів.
- При поширенні злоякісного процесу на лімфовузли, метастазуванні застосовується ад’ювантна хіміотерапія, яка забезпечує системний вплив на злоякісні клітини з будь-якою локалізацією в організмі.
- Також може застосовуватися імунотерапія – лікування моноклональними антитілами та інгібіторами імунних контрольних точок, які дозволяють активізувати природні захисні протипухлинні реакції імунітету.
- На пізніх стадіях операція може проводитися з метою паліативного лікування (циторедукція – для зменшення обсягу пухлини). Вона доповнюється хіміотерапією, імунотерапією та у деяких випадках – радіотерапією.
Повторне встановлення імпланта після операції не рекомендується. Реконструкція грудей можлива лише за рахунок аутологічних тканин і за відсутності протипоказань.
Переваги нашого центру
Спеціалізований мамологічний центр щорічно приймає тисячі пацієнтів не тільки з Києва, але й з усієї України. Ми маємо великий та безцінний практичний досвід, завдяки якому точно діагностуємо не лише поширені види раку, але й рідкісні типи онкозахворювань. Якщо ви помітили у себе будь-які симптоми, пов’язані з молочними залозами, і не знаєте, яке захворювання це може бути, – звертайтеся до нас. Ми надамо професійну допомогу у будь-якому випадку і за потреби залучимо фахівців іншого профілю для проведення спеціалізованого лікування. Записатися на прийом до мамолога у СМЦ можна вже зараз – за допомогою онлайн-форми на цій сторінці, у чаті або за телефоном.
Фахівці з анапластичної великоклітинної лімфоми
Пластичний хірург, лікар-мамолог, спеціаліст по онкохірургії
понад 27 років стажу
дивитись профіль і відгукиПластичний хірург, лікар-мамолог
понад 18 років стажу
дивитись профіль і відгукиЛікар онколог, хіміотерапевт
більше 13 років лікарського досвіду
дивитись профіль і відгукиКандидат медичних наук. Лікар-онколог, онкохірург, мамолог
білше 19 років лікарського досвіду
дивитись профіль і відгукиЛікар-хіміотерапевт, клінічний онколог
Досвід роботи за фахом 7 років.
Лікар другої категорії.
Пластичний хірург, мамолог, онкохірург, кандидат медичних наук
Має 22 роки клінічного досвіду
дивитись профіль і відгуки









